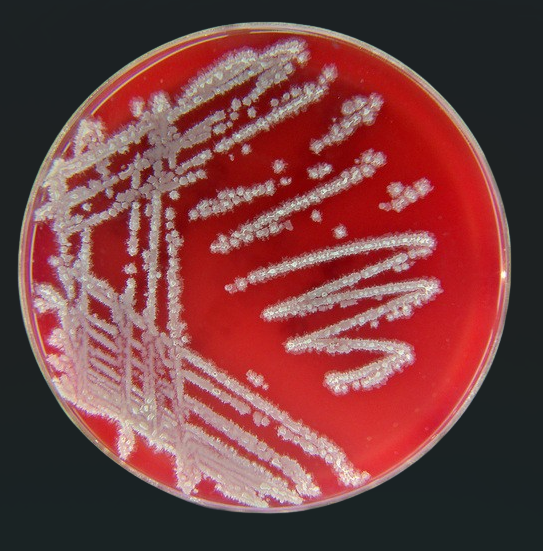
bacillus velezensis

Qué es Bacillus Licheniformis
Bacillus licheniformis es una bacteria gram positiva, formadora de esporas y naturalmente presente en el suelo y en rizosferas de múltiples cultivos. Pertenece al grupo bacillus spp, donde también se encuentran otras especies como bacillus subtilis, bacillus megaterium y bacillus amyloliquefaciens.
Es un microorganismo conocido por su capacidad para resistir condiciones extremas de salinidad, temperatura y estrés ambiental. Esta resistencia le permite colonizar ambientes agrícolas degradados y actuar como un aliado potencial en contextos de agricultura regenerativa, biofertilización y biocontrol.
Es común que se consulte en foros y entornos técnicos sobre bacillus que es, y por qué ciertas especies como bacillus licheniformis tienen tanto protagonismo en biotecnología agrícola. La respuesta está en su multifuncionalidad.
Para qué sirve Bacillus Licheniformis en agricultura
Cuando se habla de bacillus licheniformis agricultura, se hace referencia a su uso como microorganismo benéfico para mejorar la productividad, la resiliencia del cultivo y la salud del suelo. Su función puede dividirse en tres pilares:
- Promoción del crecimiento vegetal (como PGPR)
- Bioestimulación del sistema vegetal
- Biocontrol de fitopatógenos
Específicamente, bacillus licheniformis puede estimular el desarrollo de raíces, aumentar la fotosíntesis y mejorar la tolerancia al estrés salino, térmico y oxidativo. Esto se debe a que algunas cepas activan enzimas como ACC desaminasa y catalasa, que ayudan a reducir el estrés vegetal.
Bacillus licheniformis: es un caballo de batalla. Cuando sale bueno (la cepa correcta), te da robustez, enzimas, y un paquete de metabolitos que puede empujar crecimiento y/o frenar patógenos. Cuando sale “regular”, el problema no es la especie: es la variabilidad entre cepas y el riesgo toxigénico si nadie ha mirado eso con lupa.
Distribución funcional en el ecosistema agrícola
El bacillus licheniformis reparte su actividad biológica en varios frentes:

Este perfil lo convierte en una bacteria multifuncional, ideal para consorcios microbianos, y pieza clave en estrategias de agricultura regenerativa e integrativa.
Donde se encuentra en la naturaleza
Bacillus licheniformis está naturalmente presente en el suelo y en las rizosferas de múltiples cultivos. Estudios y aislamientos de campo han identificado su presencia en plantas como aloe vera, arroz, trigo, maíz, mango, pimiento, caña de azúcar y plátano, entre otros.
Su capacidad para adaptarse a condiciones de estrés térmico, salino o pobre contenido nutricional le permite colonizar eficientemente tanto cultivos tropicales como sistemas más templados.
En plantas como el aloe, se ha observado que actúa como endófito, es decir, vive dentro de los tejidos sin causar daño, lo que refuerza la idea de los «reservorios vegetales» donde estas bacterias se conservan y multiplican de forma natural.
Cómo actúa en el suelo
En campo, el rendimiento de esta bacteria depende de varios factores. El tipo de suelo, la microbiota preexistente, la formulación del producto y el manejo aplicado son determinantes para su eficacia.
Su rendimiento depende de suelo, competencia microbiana, formulación y manejo. Es de los que pueden ir “muy bien” en una finca y “meh” en otra, sin que nadie esté mintiendo.
Cuando encuentra las condiciones adecuadas, bacillus licheniformis forma biofilms potentes que se adhieren a las raíces, mejorando la retención de humedad y nutrientes. Esta propiedad también le permite competir en la rizosfera impidiendo la colonización de patógenos.

Producción de metabolitos
Una de las características más fascinantes de esta bacteria es su arsenal de compuestos antimicrobianos. Lejos de competir “a empujones”, bacillus compite con química fina.
Lichenicidin es un lantibiótico producido por algunas cepas de bacillus licheniformis, con potente actividad contra hongos y bacterias. Además, esta especie puede sintetizar lichenysin, un biosurfactante con propiedades tensioactivas valiosas para facilitar la adhesión, disolución y formación de biofilms.
Esta combinación lo convierte en un candidato serio como biocontrol natural.
Lista detallada de hongos y bacterias inhibidos
Bacillus licheniformis destaca como agente de biocontrol por su capacidad para inhibir hongos patógenos de alto impacto agrícola. Se ha documentado su eficacia contra Rhizoctonia solani, Colletotrichum gloeosporioides y Phytophthora capsici.
En cuanto a bacterias, si bien su acción antibacteriana directa no es predominante, ha mostrado buena compatibilidad en consorcios con otras PGPR como Pseudomonas fluorescens, sin efectos antagonistas.
Procesos bioquímicos precisos
Esta bacteria no solo controla patógenos: produce una gama de compuestos que tienen efecto directo sobre la fisiología vegetal. Entre ellos:
- Fitohormonas como AIA (ácido indolacético) y giberelinas.
- Lantibióticos y benzoato, con propiedades antimicrobianas.
- Sideróforos, que limitan la disponibilidad de hierro para patógenos.
- Enzimas como ACC desaminasa y catalasa, que reducen estrés oxidativo y etilénico.
Curiosidades técnicas útiles
Bacillus licheniformis puede sobrevivir en condiciones extremas de hasta 55 °C y en suelos con hasta 11 % de salinidad. Esta resistencia lo hace útil en suelos degradados o cultivos afectados por el cambio climático. Además:
- Participa activamente en los ciclos de nitrógeno, azufre y carbono, mejorando la calidad del suelo.
- Produce tiamina (vitamina B1), clave en el metabolismo energético vegetal.
- Su actividad antioxidante protege incluso en climas extremos.
Interacción con consorcios microbianos
Bacillus licheniformis no siempre actúa solo. En muchos ensayos y aplicaciones reales, se ha demostrado compatible con otras bacterias como pseudomonas fluorescens, formando consorcios microbianos estables y efectivos.
Esta noción de reservorios vegetales amplía la estrategia de manejo microbiológico, usando plantas como bancos naturales de microbios funcionales.
Bacillus licheniformis beneficios concretos
Vamos a desglosar algunos beneficios comprobados por estudios y experiencias en campo:
- Estimulación de raíces y hojas
- Aumento de clorofila y tasa fotosintética
- Producción de fitohormonas (IAA, giberelinas)
- Síntesis de sideróforos que limitan el hierro para patógenos
- Control de enfermedades como Rhizoctonia solani, Colletotrichum y Phytophthora
- Formación de biofilms resistentes
- Bioconversión de residuos: producción de queratinasas, proteasas y amilasas para degradar materia orgánica difícil
Bacillus licheniformis gram
Es una bacteria gram positiva, lo que implica una pared celular gruesa de peptidoglicano que le permite resistir ambientes extremos. Esta estructura también facilita la esporulación, lo que la hace ideal para su formulación en productos comerciales con larga vida útil.
Bacillus spp
En el grupo bacillus spp encontramos una gran diversidad de especies utilizadas en agricultura:
- Bacillus subtilis: especialista en biocontrol, genera surfactina y fengicina.
- Bacillus megaterium: excelente biofertilizante, solubiliza fósforo y produce ácido indolacético.
- Bacillus amyloliquefaciens: otro biocontrol potente con capacidad de inducir defensas vegetales.
Bacillus licheniformis se destaca por su versatilidad: puede cumplir funciones de biofertilización, biocontrol y mejora de la resiliencia vegetal, todo en uno.
Aplicaciones reales Bacillus licheniformis
Esta bacteria ha sido probada con éxito en cultivos como pimiento, arroz, trigo, maíz, fresa, mango, plátano y aloe. Se ha documentado su capacidad para aumentar la tolerancia a la sequía y mejorar la respuesta antioxidante de las plantas.
En estudios con pimientos, se observó que plantas tratadas con bacillus licheniformis sobrevivieron más tiempo bajo estrés hídrico que las no tratadas. Además, mostró capacidad para inducir proteínas específicas asociadas al estrés, demostrando una acción de tipo inmunoestimulante vegetal.
Puntos críticos para su uso
No todos los productos comerciales con bacillus licheniformis ofrecen el mismo rendimiento. Aquí algunos factores a tener en cuenta:
- Calidad y origen de la cepa
- Concentración viable de UFC
- Coformulantes utilizados
- Compatibilidad con otras bacterias o fungicidas
- Tipo de cultivo y condiciones del suelo
La experiencia de campo es clave para ajustar dosis y decidir si se aplica de forma aislada o como parte de un consorcio.
Porqué algunos lotes no funcionan
Aunque bacillus licheniformis tiene un perfil técnico excelente, en el terreno no siempre cumple lo que promete el envase. Y eso no es culpa del microbio, ni del técnico, ni del agricultor.
El rendimiento real depende de varios factores que muchas veces se pasan por alto:
- El tipo de suelo (pH, textura, materia orgánica)
- El historial de tratamientos previos (fungicidas, fertilizantes, etc.)
- La biodiversidad microbiana preexistente
- Las condiciones climáticas
- La calidad de la cepa y su formulación
No es raro ver que un bioinsumo funcione de maravilla en una finca y sea ineficaz en otra. Es de los que pueden ir “muy bien” en una finca y «no tanto» en otra, sin que nadie esté mintiendo.
Qué hace Bacillus licheniformis
Esta bacteria no es un fungicida sistémico ni un fertilizante milagroso. Su acción es sutil, biológica, progresiva, y depende de interacciones con el entorno.
Lo que sí hace (cuando funciona bien):
- Mejora el vigor general del cultivo
- Reduce ligeramente la incidencia de enfermedades por competencia
- Estimula el desarrollo radicular y fotosintético
- Hace más eficientes algunos nutrientes
- Contribuye a que el cultivo tolere mejor el estrés hídrico o térmico
Lo que no hace:
- No elimina plagas ni hongos instalados
- No reemplaza prácticas agronómicas básicas
- No mejora suelos muertos sin carbono ni estructura
- No se multiplica indefinidamente por sí sola
- No da resultados en días ni una solución rápida ante una crisis
Este tipo de microorganismos necesita planificación, coherencia y paciencia para rendir al máximo.
Cuándo sospechar que estás usando un producto mediocre
En el mercado existen decenas de formulaciones con bacillus licheniformis, pero la mayoría no te dice la cepa que contiene. Eso es una bandera roja.
Si un proveedor no especifica el número de cepa (por ejemplo, DSM 13 o ATCC XXXX), ni muestra estudios de efectividad, ni certifica la cantidad de UFC por gramo o mililitro… probablemente no tienes un producto confiable.
Algunas señales de alerta:
- El líquido huele mal, cambia de color o tiene posos extraños
- El producto no menciona la cepa específica ni origen
- El distribuidor no ofrece soporte técnico
- El mismo producto promete “todo”: nutrición, control, curación, rendimiento
Recuerda que la misma especie puede incluir cepas altamente beneficiosas o totalmente inactivas, y en casos raros, hasta potencialmente toxigénicas si no han sido bien filtradas o purificadas.
¿Qué pasa si lo aplicas mal?
Aplicar mal un bacillus como licheniformis no siempre mata el cultivo, pero sí puede generar resultados inconsistentes, pérdida de dinero y frustración.
Algunos errores comunes:
- Aplicarlo al sol del mediodía (las esporas sobreviven, pero no activas)
- Mezclarlo con fungicidas químicos incompatibles
- Inocular suelos salinos sin antes mejorar la estructura
- Usar dosis demasiado bajas “para probar”
- Repetir dosis en exceso esperando un efecto acumulativo inmediato
La clave está en integrarlo dentro de un sistema, no como producto salvavidas. Su impacto es real, pero depende de las reglas del juego biológico.
Casos reales
Aquí algunos ejemplos que pueden resonar con agricultores técnicos:
Cultivo de tomate en suelos volcánicos (altas temperaturas):
Una cepa bien formulada de bacillus licheniformis mejoró la tolerancia al calor y redujo significativamente las hojas con quemaduras por estrés. Sin embargo, la respuesta solo apareció después de 3 ciclos, no fue instantánea.
Producción de pimientos con fertirrigación intensiva:
El uso conjunto de bacillus licheniformis con bacillus subtilis y pseudomonas fluorescens logró reducir la dosis de fungicidas en un 30%, pero cuando se cambiaron las sales nitrogenadas, los efectos desaparecieron. Esto evidenció la delicada dependencia con las prácticas de manejo.
Aplicación en lotes con Fusarium dominante:
Aunque hubo una ligera disminución en la severidad de síntomas, bacillus licheniformis no logró erradicar el patógeno. El éxito parcial se asoció a la mejora del vigor vegetal más que a un efecto directo antifúngico.
Cómo usarlo de forma responsable
Para que esta bacteria sea una aliada real y no una promesa vacía, te recomiendo:
- Pedir siempre la cepa específica (nunca compres un producto sin esto)
- Verificar si hay estudios publicados o fichas técnicas reales
- Aplicarlo en fases clave del cultivo: pretrasplante, emergencia radicular, floración
- No mezclarlo con productos ácidos o tóxicos sin consulta previa
- Dar seguimiento técnico real, no solo “echarlo” y esperar
El futuro: menos productos, más estrategias
Lo interesante de bacillus licheniformis no es venderlo como “el microbio milagro”, sino integrarlo en estrategias de transición agroecológica, restauración de suelos y reducción de insumos químicos.
Su verdadero potencial no está solo en lo que hace, sino en con quién lo acompañas, cómo lo manejas y cómo mides su impacto.
Conclusión
Bacillus licheniformis es una herramienta potente, pero como toda solución biológica, su eficacia depende del contexto. Cuando se selecciona bien la cepa y se maneja con conocimiento, ofrece un abanico de beneficios que incluyen promoción del crecimiento, protección frente a enfermedades, mejora del suelo y reducción de insumos químicos.
Pero no se trata de un “milagro embotellado”. Se trata de microbiología aplicada con inteligencia.
Si te interesa profundizar más en cómo integrar microorganismos de forma efectiva en tu finca, podemos ayudarte a diseñar estrategias reales, adaptadas a tu contexto, y no fórmulas de laboratorio aplicadas a ciegas.
Si no solo buscas mejorar resultados sino el límite a la producción
Si quieres diferenciarte de verdad tener más control y menos dependencia, ¡ podemos ayudarte !
Elige uno de nuestros servicios (consultoría, asesoría, análisis y formación) para avanzar hacia una agricultura más eficiente y sostenible
y vemos qué encaja para ti
Imagen de Bacillus licheniformis bajo microscopio.
Crédito: Ansel Oommen vía iNaturalist (CC BY-NC)